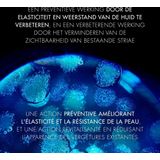
Biotherm Biovergetures

Auto'sBaby & peuterBoekenCadeaus & gadgetsComputersDierenbenodigdhedenDrogisterijElektronicaErotiekEten & drinkenFietsenFilms & SeriesGamesHorlogesHuishoudelijkKantoorKledingKlussenMeubelsMode accessoiresMultimedia-accessoiresMuziekinstrumentenParfumerieSanitairSchoenenSieradenSoftwareSpeelgoedSport & OutdoorTuinartikelenWoonaccessoires
Als laatst door jou gezocht
0Cookies op beslist.nl
Beslist.nl gebruikt functionele en analytische cookies voor website optimalisatie en statistieken. Verder gebruiken wij en eventuele partners cookies om persoonlijke aanbevelingen en advertenties te tonen binnen en buiten onze website. Als je op “Accepteren” klikt, dan geef je beslist.nl toestemming om cookies gepersonaliseerde advertenties te plaatsen. Kies je voor “Weigeren”, dan plaatsen we alleen functionele en analytische cookies. Lees hier meer over in onze cookieverklaring en ons privacybeleid. In de cookieverklaring lees je ook hoe je de cookies kunt intrekken.
Biotherm Biovergetures
3/5 (3 reviews)

+5
Flaconi.nl
€28,19
Gratis verzending | 2-3 dagen
208.80/1000 ml
Laagste totaalprijs
Gratis retour
Bekijk
Bekijk
bol.com
€29,45
€35,70
Gratis verzending | 2 dagen
Gratis retour
Bekijk
Bekijk
Douglas.nl
€33,15
€51,-
Gratis verzending | 1 dag
Hoge korting
Gratis retour
Bekijk
Bekijk
Anderen bekeken ook
Prijsontwikkeling
Is de huidige prijs een goede deal? De grafiek toont de laagste prijs per dag, exclusief verzendkosten.
Laagste prijsSpecificaties
MerkBiotherm
DoelgroepDames, Volwassenen
TypeLotions
Inhoud150 ml
Beschrijving
Biotherm Biovergetures bodygel voor vrouwen heeft een bijzonder verkoelende, hydraterende en ontzwellende werking op het lichaam. Dit Biotherm product is verkrijgbaar in de maten 150 milliliter (ml). Biotherm Biovergetures is geschikt voor alle huidtypes en de normale huid.
Trending
EOS BodylotionsRituals BodylotionsNivea BodylotionsVaseline BodylotionsParfumvrije BodylotionsChanel BodylotionsKruidvat BodylotionsNarciso Rodriguez BodylotionsGarnier BodylotionsMugler BodylotionsJanzen Bodylotions DamesBodylotions zonder parabenenRituals Bodylotions DamesBiotherm BodylotionsEucerin BodylotionsHUGO BOSS BodylotionsNeutral BodylotionsCeraVe BodylotionsBiotherm Bodylotions LotionsTherme BodylotionsKneipp BodylotionsCaudalie BodylotionsOlay BodylotionsCaudalie Bodylotion 200 mlDove BodylotionsHypoallergene Bodylotions Gevoelige huidMarbert BodylotionsSebamed BodylotionsBodylotions MannenGloria Vanderbilt BodylotionsCollistar BodylotionsO'Keeffe's BodylotionsClarins BodylotionsMaja bodylotions LotionsLa Roche-Posay BodylotionsMaroussia BodylotionsMaja BodylotionsJean Paul Gaultier BodylotionsMixa Bodylotions Baby's Gevoelige huid 300 mlLancome BodylotionsRituals Bodylotions MannenMixa BodylotionsJil Sander BodylotionsJohnson & Johnson BodylotionsNivea Bodylotions MannenBurberry BodylotionsHypoallergene BodylotionsL'Occitane BodylotionsBoucheron BodylotionsGiorgio Armani BodylotionsVichy BodylotionsHeno de Pravia BodylotionsYves Rocher Bodylotions Droge huid Crèmes 100 mlInecto BodylotionsYves Rocher Bodylotions Oliën 100 mlBaby creme, baby lotion, baby bodylotionThierry Mugler BodylotionsDove Bodylotions Zeer droge huidAmouage BodylotionsYves Saint Laurent BodylotionsLancaster BodylotionsHermes BodylotionsElie Saab BodylotionsJanzen BodylotionsNeutrogena BodylotionsParfumvrije Bodylotion voor Oudere HuidEtos BodylotionsThe Spa Collection BodylotionsFenjal BodylotionsCetaphil BodylotionsGarnier Bodylotions DamesNUXE BodylotionsAlyssa Ashley Bodylotions 750 mlClarins Bodylotions Oudere huid CrèmesBarnängen BodylotionsZwitsal BodylotionsBalneum BodylotionsThe Spa Collection Bodylotions Lotions 2 stVan Gils BodylotionsBodylotions SpraysBabaria BodylotionsIssey Miyake BodylotionsPalmolive BodylotionsSanex BodylotionsYves Saint Laurent Bodylotions 200 mlTopicrem bodylotions 500 mlShea Moisture Plantaardig bodylotionsMarc Jacobs BodylotionsEveline Cosmetics BodylotionsISDIN BodylotionsEstee Lauder BodylotionsBurts Bees BodylotionsAesop BodylotionsBodylotions GelsBodylotions Douglas.nlDiadermine BodylotionsDKNY BodylotionsLaura Biagiotti BodylotionsHema BodylotionsFa Bodylotions
Algemeen
Bestellen op beslist.nl
Bestellen & leveringRetournerenKlachtenVoorwaarden winkelwagen
Vergelijken • kiezen • kopen
Bij beslist.nl vergelijk je snel prijzen en producten van duizenden webshops. Als de grootste vergelijkingssite van Nederland helpen wij consumenten al meer dan 20 jaar met het vinden van de beste aanbiedingen en producten. Met een assortiment van meer dan 80 miljoen producten maken we jouw online winkelervaring zo makkelijk mogelijk.
Zoek je een product dat morgen in huis is? Wil je de laagste prijs of snel prijzen vergelijken van verschillende aanbieders? Online shoppen begint bij beslist.nl!
De prijzen van de getoonde producten op beslist.nl zijn incl. BTW en exclusief eventueel bijkomende verzendkosten.
